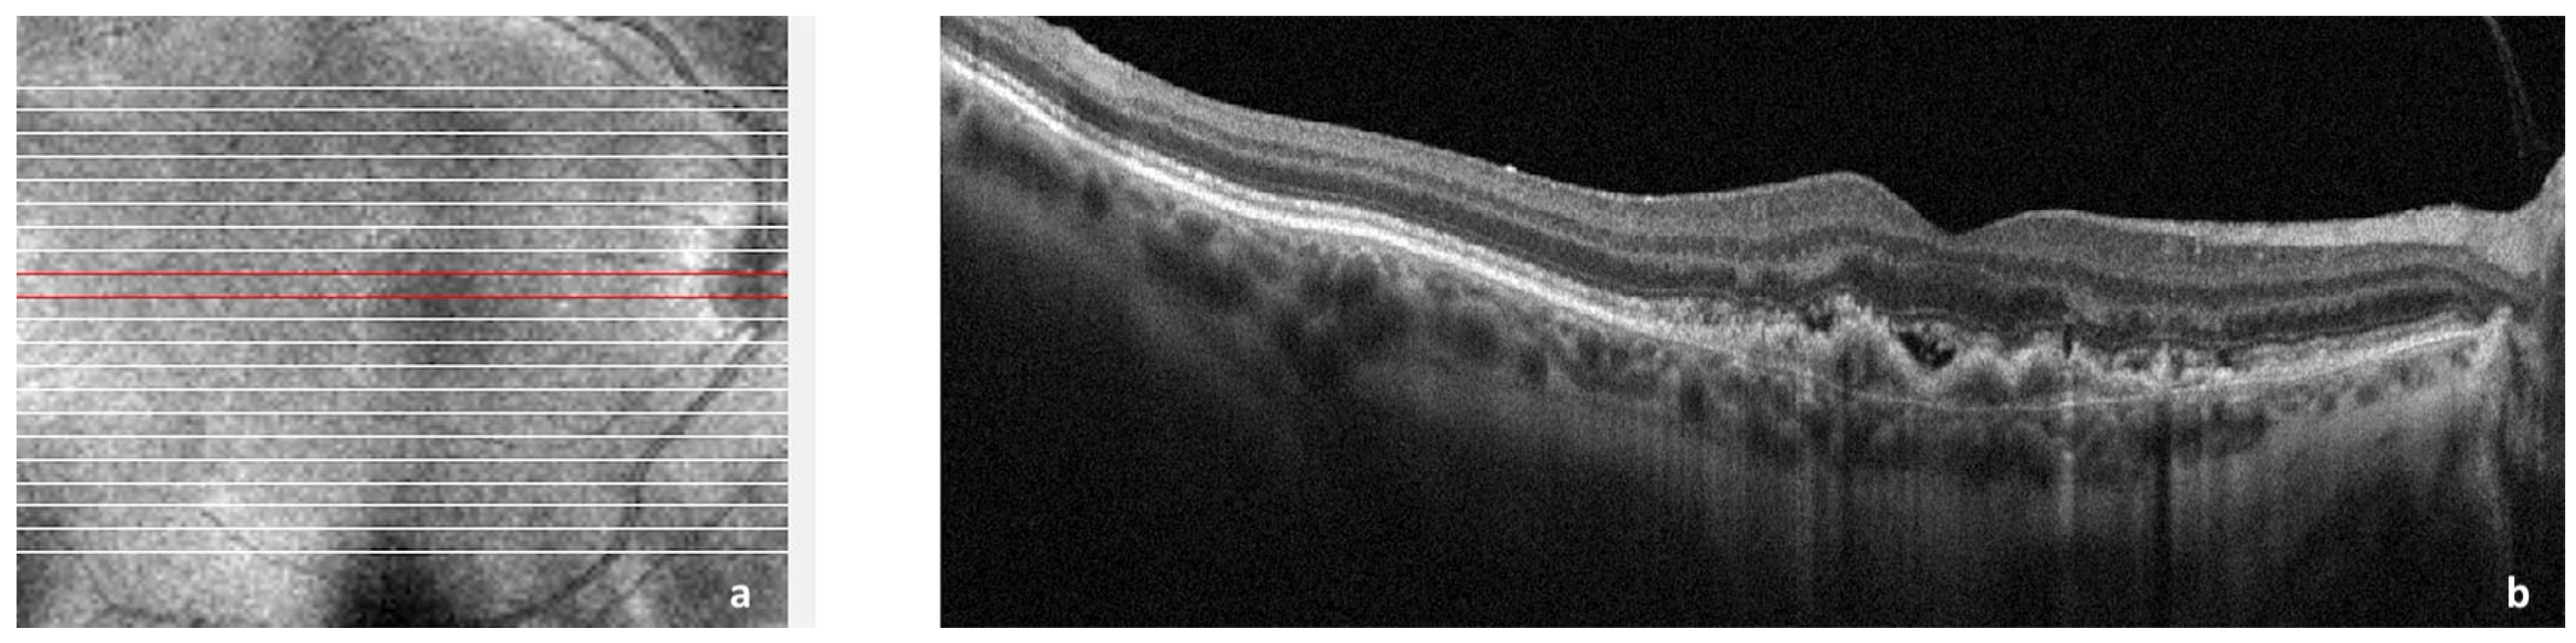

Choroidal Neovascular Membranes in Retinal and Choroidal Tumors: Origins, Mechanisms, and Effects
Abstract
1. Introduction
2. Results
2.1. Choroidal Neovascularization Mechanism in In-Vivo and In-Vitro Models
2.2. Vascular Mechanisms in Choroidal Neovascularization
2.3. Molecular Mechanisms
2.4. CNV Associated with Choroidal Nevi and Melanomas
2.5. CNV in Choroidal Osteoma
2.6. CNV in Choroidal Hemangioma
2.7. CNV in Primary Vitreous Retinal Lymphoma
3. Discussion
Author Contributions
Funding
Institutional Review Board Statement
Informed Consent Statement
Data Availability Statement
Conflicts of Interest
References
- Maheshwari, A.; Finger, P.T. Cancers of the eye. Cancer Metastasis Rev. 2018, 37, 677–690. [Google Scholar] [CrossRef] [PubMed]
- Naumann, G.; Yanoff, M.; Zimmerman, L.E. Histogenesis of Malignant Melanomas of the Uvea: I. Histopathologic Characteristics of Nevi of the Choroid and Ciliary Body. Arch. Ophthalmol. 1966, 76, 784–796. [Google Scholar] [CrossRef] [PubMed]
- Mines, J.A.; Freilich, D.B.; Friedman, A.H.; Lazar, M. Choroidal (Subretinal) Neovascularization Secondary to Choroidal Nevus and Successful Treatment with Argon Laser Photocoagulation. Ophthalmologica 1985, 190, 210–218. [Google Scholar] [CrossRef]
- Waltman, D.D.; Gitter, A.K.; Yannuzzi, L.; Schatz, H. Choroidal Neovascularization Associated with Choroidal Nevi. Am. J. Ophthalmol. 1978, 85, 704–710. [Google Scholar] [CrossRef] [PubMed]
- Lubin, J.R.; Gragoudas, E.S.; Albert, D.M. Choroidal Neovascularization Associated with Malignant Melanoma. Acta Ophthalmol. 1982, 60, 412–418. [Google Scholar] [CrossRef] [PubMed]
- Mearza, A.A.; Harsum, S.; Hiscott, P.; Chopdar, A. Choroidal neovascular membrane associated with malignant melanoma presenting as angle closure glaucoma. Acta Ophthalmol. Scand. 2004, 82, 628–630. [Google Scholar] [CrossRef]
- Zhang, Y. Secondary choroidal neovascularization due to choroidal osteoma after 9 years follow-up. BMC Ophthalmol. 2021, 21, 242. [Google Scholar] [CrossRef]
- Ng, E.W.M.; Adamis, A.P. Targeting angiogenesis, the underlying disorder in neovascular age-related macular degeneration. Can. J. Ophthalmol. 2005, 40, 352–368. [Google Scholar] [CrossRef]
- Fleckenstein, M.; Keenan, T.D.L.; Guymer, R.H.; Chakravarthy, U.; Schmitz-Valckenberg, S.; Klaver, C.C.; Wong, W.T.; Chew, E.Y. Age-related macular degeneration. Nat. Rev. Dis. Primer. 2021, 7, 31. [Google Scholar] [CrossRef]
- Rozing, M.P.; Durhuus, J.A.; Krogh Nielsen, M.; Subhi, Y.; Kirkwood, T.B.; Westendorp, R.G.; Sørensen, T.L. Age-related macular degeneration: A two-level model hypothesis. Prog. Retin. Eye Res. 2020, 76, 100825. [Google Scholar] [CrossRef]
- Spaide, R.F.; Jaffe, G.J.; Sarraf, D.; Freund, K.B.; Sadda, S.R.; Staurenghi, G.; Waheed, N.K.; Chakravarthy, U.; Rosenfeld, P.J.; Holz, F.G.; et al. Consensus Nomenclature for Reporting Neovascular Age-Related Macular Degeneration Data: Consensus on Neovascular Age-Related Macular Degeneration Nomenclature Study Group. Ophthalmology 2020, 127, 616–636. [Google Scholar] [CrossRef] [PubMed]
- Macular Photocoagulation Study Group. Laser Photocoagulation of Subfoveal Recurrent Neovascular Lesions in Age-Related Macular Degeneration: Results of a Randomized Clinical Trial. Arch. Ophthalmol. 1991, 109, 1232–1241. [Google Scholar] [CrossRef]
- Gass, J.D.M. Biomicroscopic and Histopathologic Considerations Regarding the Feasibility of Surgical Excision of Subfoveal Neovascular Membranes. Am. J. Ophthalmol. 1994, 118, 285–298. [Google Scholar] [CrossRef] [PubMed]
- Lafaut, B.A.; Bartz-Schmidt, K.U.; Broecke, C.V.; Aisenbrey, S.; Laey, J.J.D.; Heimann, K. Clinicopathological correlation in exudative age related macular degeneration: Histological differentiation between classic and occult choroidal neovascularisation. Br. J. Ophthalmol. 2000, 84, 239–243. [Google Scholar] [CrossRef]
- Yeo, N.J.Y.; Chan, E.J.J.; Cheung, C. Choroidal Neovascularization: Mechanisms of Endothelial Dysfunction. Front. Pharmacol. 2019, 10, 1363. [Google Scholar] [CrossRef]
- Grossniklaus, H.E.; Kang, S.J.; Berglin, L. Animal models of choroidal and retinal neovascularization. Prog. Retin. Eye Res. 2010, 29, 500–519. [Google Scholar] [CrossRef] [PubMed]
- Lambert, V.; Lecomte, J.; Hansen, S.; Blacher, S.; Gonzalez, M.-L.A.; Struman, I.; Sounni, N.E.; Rozet, E.; de Tullio, P.; Foidart, J.M.; et al. Laser-induced choroidal neovascularization model to study age-related macular degeneration in mice. Nat. Protoc. 2013, 8, 2197–2211. [Google Scholar] [CrossRef] [PubMed]
- Tolentino, M.J.; Brucker, A.J.; Fosnot, J.; Ying, G.-S.; Wu, I.-H.; Malik, G.; Wan, S.; Reich, S.J. Intravitreal injection of vascular endothelial growth factor small interfering rna inhibits growth and leakage in a nonhuman primate, laser-induced model of choroidal neovascularization. Retina 2004, 24, 132–138. [Google Scholar] [CrossRef]
- Jones, C.A.; London, N.R.; Chen, H.; Park, K.W.; Sauvaget, D.; Stockton, R.A.; Wythe, J.D.; Suh, W.; Larrieu-Lahargue, F.; Mukouyama, Y.; et al. Robo4 stabilizes the vascular network by inhibiting pathologic angiogenesis and endothelial hyperpermeability. Nat. Med. 2008, 14, 448–453. [Google Scholar] [CrossRef]
- Kwak, N.; Okamoto, N.; Wood, J.M.; Campochiaro, P.A. VEGF Is Major Stimulator in Model of Choroidal Neovascularization. Investig. Ophthalmol. Vis. Sci. 2000, 41, 3158–3164. [Google Scholar]
- Ogata, N.; Matsushima, M.; Takada, Y.; Tobe, T.; Takahashi, K.; Yi, X.; Yamamoto, C.; Yamada, H.; Uyama, M. Expression of basic fibroblast growth factor mRNA in developing choroidal neovascularization. Curr. Eye Res. 1996, 15, 1008–1018. [Google Scholar] [CrossRef] [PubMed]
- Yi, X.; Ogata, N.; Komada, M.; Yamamoto, C.; Takahashi, K.; Omori, K.; Uyama, M. Vascular endothelial growth factor expression in choroidal neovascularization in rats. Graefes Arch. Clin. Exp. Ophthalmol. 1997, 235, 313–319. [Google Scholar] [CrossRef] [PubMed]
- Tobe, T.; Ortega, S.; Luna, J.D.; Ozaki, H.; Okamoto, N.; Derevjanik, N.L.; Vinores, S.A.; Basilico, C.; Campochiaro, P.A. Targeted Disruption of the FGF2 Gene Does Not Prevent Choroidal Neovascularization in a Murine Model. Am. J. Pathol. 1998, 153, 1641–1646. [Google Scholar] [CrossRef] [PubMed]
- Yamada, H.; Yamada, E.; Hackett, S.F.; Ozaki, H.; Okamoto, N.; Campochiaro, P.A. Hyperoxia causes decreased expression of vascular endothelial growth factor and endothelial cell apoptosis in adult retina. J. Cell. Physiol. 1999, 179, 149–156. [Google Scholar] [CrossRef]
- Wang, X.; Ma, W.; Han, S.; Meng, Z.; Zhao, L.; Yin, Y.; Wang, Y.; Li, J. TGF-β participates choroid neovascularization through Smad2/3-VEGF/TNF-α signaling in mice with Laser-induced wet age-related macular degeneration. Sci. Rep. 2017, 7, 9672. [Google Scholar] [CrossRef]
- Yan, Z.; Shi, H.; Zhu, R.; Li, L.; Qin, B.; Kang, L.; Chen, H.; Guan, H. Inhibition of YAP ameliorates choroidal neovascularization via inhibiting endothelial cell proliferation. Mol. Vis. 2018, 24, 83–93. [Google Scholar]
- Pennesi, M.E.; Neuringer, M.; Courtney, R.J. Animal models of age related macular degeneration. Mol. Asp. Med. 2012, 33, 487–509. [Google Scholar] [CrossRef]
- Rops, A.L.; van der Vlag, J.; Jacobs, C.W.; Dijkman, H.B.; Lensen, J.F.; Wijnhoven, T.J.; van den Heuvel, L.P.; van Kuppevelt, T.H.; Berden, J.H. Isolation and characterization of conditionally immortalized mouse glomerular endothelial cell lines. Kidney Int. 2004, 66, 2193–2201. [Google Scholar] [CrossRef]
- Giacalone, J.C.; Miller, M.J.; Workalemahu, G.; Reutzel, A.J.; Ochoa, D.; Whitmore, S.S.; Stone, E.M.; Tucker, B.A.; Mullins, R.F. Generation of an immortalized human choroid endothelial cell line (iChEC-1) using an endothelial cell specific promoter. Microvasc. Res. 2019, 123, 50–57. [Google Scholar] [CrossRef]
- Chichagova, V.; Hallam, D.; Collin, J.; Zerti, D.; Dorgau, B.; Felemban, M.; Lako, M.; Steel, D.H. Cellular regeneration strategies for macular degeneration: Past, present and future. Eye 2018, 32, 946–971. [Google Scholar] [CrossRef]
- Ishibashi, T.; Miller, H.; Orr, G.; Sorgente, N.; Ryan, S.J. Morphologic observations on experimental subretinal neovascularization in the monkey. Investig. Ophthalmol. Vis. Sci. 1987, 28, 1116–1130. [Google Scholar]
- Asahara, T.; Murohara, T.; Sullivan, A.; Silver, M.; van der Zee, R.; Li, T.; Witzenbichler, B.; Schatteman, G.; Isner, J.M. Isolation of putative progenitor endothelial cells for angiogenesis. Science 1997, 275, 964–967. [Google Scholar] [CrossRef] [PubMed]
- Asahara, T.; Masuda, H.; Takahashi, T.; Kalka, C.; Pastore, C.; Silver, M.; Kearne, M.; Magner, M.; Isner, J.M. Bone marrow origin of endothelial progenitor cells responsible for postnatal vasculogenesis in physiological and pathological neovascularization. Circ. Res. 1999, 85, 221–228. [Google Scholar] [CrossRef] [PubMed]
- Sengupta, N.; Caballero, S.; Mames, R.N.; Butler, J.M.; Scott, E.W.; Grant, M.B. The role of adult bone marrow-derived stem cells in choroidal neovascularization. Investig. Ophthalmol. Vis. Sci. 2003, 44, 4908–4913. [Google Scholar] [CrossRef] [PubMed]
- Tomita, M.; Yamada, H.; Adachi, Y.; Cui, Y.; Yamada, E.; Higuchi, A.; Minamino, K.; Suzuki, Y.; Matsumura, M.; Ikehara, S. Choroidal neovascularization is provided by bone marrow cells. Stem Cells Dayt. Ohio 2004, 22, 21–26. [Google Scholar] [CrossRef]
- Espinosa-Heidmann, D.G.; Reinoso, M.A.; Pina, Y.; Csaky, K.G.; Caicedo, A.; Cousins, S.W. Quantitative enumeration of vascular smooth muscle cells and endothelial cells derived from bone marrow precursors in experimental choroidal neovascularization. Exp. Eye Res. 2005, 80, 369–378. [Google Scholar] [CrossRef]
- Hou, H.-Y.; Wang, Y.-S.; Xu, J.-F.; Wang, Y.-C.; Liu, J.-P. The dynamic conduct of bone marrow-derived cells in the choroidal neovascularization microenvironment. Curr. Eye Res. 2006, 31, 1051–1061. [Google Scholar] [CrossRef]
- Chan-Ling, T.; Baxter, L.; Afzal, A.; Sengupta, N.; Caballero, S.; Rosinova, E.; Grant, M.B. Hematopoietic stem cells provide repair functions after laser-induced Bruch’s membrane rupture model of choroidal neovascularization. Am. J. Pathol. 2006, 168, 1031–1044. [Google Scholar] [CrossRef]
- Grant, M.B.; May, W.S.; Caballero, S.; Brown, G.A.J.; Guthrie, S.M.; Mames, R.N.; Byrne, B.J.; Vaught, T.; Spoerri, P.E.; Peck, A.B.; et al. Adult hematopoietic stem cells provide functional hemangioblast activity during retinal neovascularization. Nat. Med. 2002, 8, 607–612. [Google Scholar] [CrossRef]
- Sheridan, C.M.; Rice, D.; Hiscott, P.S.; Wong, D.; Kent, D.L. The presence of AC133-positive cells suggests a possible role of endothelial progenitor cells in the formation of choroidal neovascularization. Investig. Ophthalmol. Vis. Sci. 2006, 47, 1642–1645. [Google Scholar] [CrossRef][Green Version]
- Gao, F.; Hou, H.; Liang, H.; Weinreb, R.N.; Wang, H.; Wang, Y. Bone marrow-derived cells in ocular neovascularization: Contribution and mechanisms. Angiogenesis 2016, 19, 107–118. [Google Scholar] [CrossRef] [PubMed]
- Zhang, Z.-X.; Wang, Y.-S.; Shi, Y.-Y.; Hou, H.-Y.; Zhang, C.; Cai, Y.; Dou, G.-R.; Yao, L.-B.; Li, F.-Y. Hypoxia specific SDF-1 expression by retinal pigment epithelium initiates bone marrow-derived cells to participate in Choroidal neovascularization in a laser-induced mouse model. Curr. Eye Res. 2011, 36, 838–849. [Google Scholar] [CrossRef] [PubMed]
- Okuno, Y.; Nakamura-Ishizu, A.; Kishi, K.; Suda, T.; Kubota, Y. Bone marrow-derived cells serve as proangiogenic macrophages but not endothelial cells in wound healing. Blood 2011, 117, 5264–5272. [Google Scholar] [CrossRef] [PubMed]
- Purhonen, S.; Palm, J.; Rossi, D.; Kaskenpää, N.; Rajantie, I.; Ylä-Herttuala, S.; Alitalo, K.; Weissman, I.L.; Salven, P. Bone marrow-derived circulating endothelial precursors do not contribute to vascular endothelium and are not needed for tumor growth. Proc. Natl. Acad. Sci. USA 2008, 105, 6620–6625. [Google Scholar] [CrossRef]
- Naito, H.; Kidoya, H.; Sakimoto, S.; Wakabayashi, T.; Takakura, N. Identification and characterization of a resident vascular stem/progenitor cell population in preexisting blood vessels. EMBO J. 2012, 31, 842–855. [Google Scholar] [CrossRef]
- Wakabayashi, T.; Naito, H.; Takara, K.; Kidoya, H.; Sakimoto, S.; Oshima, Y.; Nishida, K.; Takakura, N. Identification of vascular endothelial side population cells in the choroidal vessels and their potential role in age-related macular degeneration. Investig. Ophthalmol. Vis. Sci. 2013, 54, 6686–6693. [Google Scholar] [CrossRef]
- Ferrara, N.; Houck, K.A.; Jakeman, L.B.; Winer, J.; Leung, D.W. The vascular endothelial growth factor family of polypeptides. J. Cell. Biochem. 1991, 47, 211–218. [Google Scholar] [CrossRef]
- Papadopoulos, N.; Martin, J.; Ruan, Q.; Rafique, A.; Rosconi, M.P.; Shi, E.; Pyles, E.A.; Yancopoulos, G.D.; Stahl, N.; Wie-gand, S.J. Binding and neutralization of vascular endothelial growth factor (VEGF) and related ligands by VEGF Trap, ranibizumab and bevacizumab. Angiogenesis 2012, 15, 171–185. [Google Scholar] [CrossRef]
- Kinnunen, K.; Ylä-Herttuala, S. Vascular endothelial growth factors in retinal and choroidal neovascular diseases. Ann. Med. 2012, 44, 1–17. [Google Scholar] [CrossRef]
- Anand-Apte, B.; Hollyfield, J.G. Developmental Anatomy of the Retinal and Choroidal Vasculature. In Encyclopedia of the Eye; Dartt, D.A., Ed.; Academic Press: Oxford, UK, 2010; pp. 9–15. Available online: https://www.sciencedirect.com/science/article/pii/B978012374203200169X (accessed on 2 January 2023).
- Marneros, A.G.; Fan, J.; Yokoyama, Y.; Gerber, H.P.; Ferrara, N.; Crouch, R.K.; Olsen, B.R. Vascular endothelial growth factor expression in the retinal pigment epithelium is essential for choriocapillaris development and visual function. Am. J. Pathol. 2005, 167, 1451–1459. [Google Scholar] [CrossRef]
- Ishida, S.; Usui, T.; Yamashiro, K.; Kaji, Y.; Amano, S.; Ogura, Y.; Hida, T.; Oguchi, Y.; Ambati, J.; Miller, J.W.; et al. VEGF164-mediated inflammation is required for pathological, but not physiological, ischemia-induced retinal neovascularization. J. Exp. Med. 2003, 198, 483–489. [Google Scholar] [CrossRef] [PubMed]
- Zhang, L.; Lim, S.L.; Du, H.; Zhang, M.; Kozak, I.; Hannum, G.; Wang, X.; Ouyang, H.; Hughes, G.; Zhao, L.; et al. High temperature requirement factor A1 (HTRA1) gene regulates angiogenesis through transforming growth factor-β family member growth differentiation factor 6. J. Biol. Chem. 2012, 287, 1520–1526. [Google Scholar] [CrossRef] [PubMed]
- Yang, Z.; Camp, N.J.; Sun, H.; Tong, Z.; Gibbs, D.; Cameron, D.J.; Chen, H.; Zhao, Y.; Pearson, E.; Li, X.; et al. A variant of the HTRA1 gene increases susceptibility to age-related macular degeneration. Science 2006, 314, 992–993. [Google Scholar] [CrossRef] [PubMed]
- Dong, A.; Xie, B.; Shen, J.; Yoshida, T.; Yokoi, K.; Hackett, S.F.; Campochiaro, P.A. Oxidative stress promotes ocular neovascularization. J. Cell. Physiol. 2009, 219, 544–552. [Google Scholar] [CrossRef]
- Supanji; Shimomachi, M.; Hasan, M.Z.; Kawaichi, M.; Oka, C. HtrA1 is induced by oxidative stress and enhances cell senescence through p38 MAPK pathway. Exp. Eye Res. 2013, 112, 79–92. [Google Scholar] [CrossRef]
- Marazita, M.C.; Dugour, A.; Marquioni-Ramella, M.D.; Figueroa, J.M.; Suburo, A.M. Oxidative stress-induced premature senescence dysregulates VEGF and CFH expression in retinal pigment epithelial cells: Implications for Age-related Macular Degeneration. Redox Biol. 2016, 7, 78–87. [Google Scholar] [CrossRef]
- Kaarniranta, K.; Kajdanek, J.; Morawiec, J.; Pawlowska, E.; Blasiak, J. PGC-1α Protects RPE Cells of the Aging Retina against Oxidative Stress-Induced Degeneration through the Regulation of Senescence and Mitochondrial Quality Control. The Significance for AMD Pathogenesis. Int. J. Mol. Sci. 2018, 19, 2317. [Google Scholar] [CrossRef]
- Singer, M.A.; Awh, C.C.; Sadda, S.; Freeman, W.R.; Antoszyk, A.N.; Wong, P.; Tuomi, L. HORIZON: An open-label extension trial of ranibizumab for choroidal neovascularization secondary to age-related macular degeneration. Ophthalmology 2012, 119, 1175–1183. [Google Scholar] [CrossRef]
- Rofagha, S.; Bhisitkul, R.B.; Boyer, D.S.; Sadda, S.R.; Zhang, K.; SEVEN-UP Study Group. Seven-year outcomes in ranibizumab-treated patients in ANCHOR, MARINA, and HORIZON: A multicenter cohort study (SEVEN-UP). Ophthalmology 2013, 120, 2292–2299. [Google Scholar] [CrossRef]
- Silva, R.; Axer-Siegel, R.; Eldem, B.; Guymer, R.; Kirchhof, B.; Papp, A.; Seres, A.; Gekkieva, M.; Nieweg, A.; Pilz, S.; et al. The SECURE study: Long-term safety of ranibizumab 0.5 mg in neovascular age-related macular degeneration. Ophthalmology 2013, 120, 130–139. [Google Scholar] [CrossRef]
- Reinmuth, N.; Liu, W.; Jung, Y.D.; Ahmad, S.A.; Shaheen, R.M.; Fan, F.; Bucana, C.D.; McMahon, G.; Gallick, G.E.; Ellis, L.M. Induction of VEGF in perivascular cells defines a potential paracrine mechanism for endothelial cell survival. FASEB J. Off. Publ. Fed. Am. Soc. Exp. Biol. 2001, 15, 1239–1241. [Google Scholar] [CrossRef] [PubMed]
- Franco, M.; Roswall, P.; Cortez, E.; Hanahan, D.; Pietras, K. Pericytes promote endothelial cell survival through induction of autocrine VEGF-A signaling and Bcl-w expression. Blood 2011, 118, 2906–2917. [Google Scholar] [CrossRef] [PubMed]
- Pachydaki, S.I.; Jakobiec, F.A.; Bhat, P.; Sobrin, L.; Michaud, N.A.; Seshan, S.V.; D’Amico, D.J. Surgical management and ultrastructural study of choroidal neovascularization in punctate inner choroidopathy after bevacizumab. J. Ophthalmic Inflamm. Infect. 2012, 2, 29–37. [Google Scholar] [CrossRef] [PubMed]
- Gonder, J.R.; Augsburger, J.J.; McCarthy, E.F.; Shields, J.A. Visual loss associated with choroidal nevi. Ophthalmology 1982, 89, 961–965. [Google Scholar] [CrossRef]
- Rouic, L.L.-L. Mélanome Choroïdien: Aspect Clinique au Diagnostic et après Traitement (Choroidal Melanoma: Clinical Aspect at Diagnosis and after Treatment). Images en Ophtalmologie [Internet]. Edimark.fr, Vol. I, n. 1. Octo-Bre-Novembre-Décembre 2007. Available online: https://www.edimark.fr/images-ophtalmologie/melanome-choroidien-aspect-clinique-diagnostic-apres-traitement (accessed on 2 January 2023).
- Zografos, L.; Mantel, I.; Schalenbourg, A. Subretinal Choroidal Neovascularization Associated with Choroidal Nevus. Eur. J. Ophthalmol. 2004, 14, 123–131. [Google Scholar] [CrossRef]
- Singh, A.D.; Bergman, L.; Seregard, S. Uveal melanoma: Epidemiologic aspects. Ophthalmol. Clin. N. Am. 2005, 18, 75–84. [Google Scholar] [CrossRef]
- Hu, D.-N.; Yu, G.-P.; McCormick, S.A. Population-based incidence of vulvar and vaginal melanoma in various races and ethnic groups with comparisons to other site-specific melanomas. Melanoma Res. 2010, 20, 153–158. [Google Scholar] [CrossRef]
- Finger, P.T. Eye: Choroidal melanoma, retinoblastoma, ocular adnexal lymphoma and eyelid cancers. In UICC Manual of Clinical Oncology; John Wiley & Sons, Ltd.: Hoboken, NJ, USA, 2015; pp. 726–744. Available online: https://onlinelibrary.wiley.com/doi/abs/10.1002/9781119013143.ch56 (accessed on 2 January 2023).
- Guerin, E.; Hiscott, P.; Damato, B. Choroidal neovascular membrane in a series of cases of malignant melanoma of the choroid. ACTA Ophthalmol. Scand. 2006, 84, 323–327. [Google Scholar] [CrossRef]
- Tuncer, S.; Tugal-Tutkun, I. Choroidal neovascularization secondary to choroidal nevus simulating an inflammatory lesion. Indian J. Ophthalmol. 2013, 61, 305–306. [Google Scholar] [CrossRef]
- Shields, C.L.; Shields, J.A.; Augsburger, J.J. Choroidal osteoma. Surv. Ophthalmol. 1988, 33, 17–27. [Google Scholar] [CrossRef]
- Grand, M.G.; Burgess, D.B.; Singerman, L.J.; Ramsey, J. Choroidal osteoma. Treatment of associated subretinal neovascular membranes. Retina 1984, 4, 84–89. [Google Scholar] [CrossRef] [PubMed]
- Foster, B.S.; Fernandez-Suntay, J.P.; Dryja, T.P.; Jakobiec, F.A.; D’Amico, D.J. Clinicopathologic reports, case reports, and small case series: Surgical removal and histopathologic findings of a subfoveal neovascular membrane associated with choroidal osteoma. Arch. Ophthalmol. 2003, 121, 273–276. [Google Scholar] [CrossRef] [PubMed]
- Aylward, G.W.; Chang, T.S.; Pautler, S.E.; Gass, J.D. A long-term follow-up of choroidal osteoma. Arch. Ophthalmol. 1998, 116, 1337–1341. [Google Scholar] [CrossRef] [PubMed]
- Shields, C.L.; Sun, H.; Demirci, H.; Shields, J.A. Factors predictive of tumor growth, tumor decalcification, choroidal neovascularization, and visual outcome in 74 eyes with choroidal osteoma. Arch. Ophthalmol. 2005, 123, 1658–1666. [Google Scholar] [CrossRef] [PubMed]
- Naik, A.U.; Raman, R. Bilateral Choroidal Osteomas with Choroidal Neovascularization. JAMA Ophthalmol. 2020, 138, e190059. [Google Scholar] [CrossRef] [PubMed]
- Kim, D.; Ryu, G.; Sagong, M. Polypoidal choroidal vasculopathy as a complication of choroidal osteoma: A case report. Medicine 2020, 99, e19927. [Google Scholar] [CrossRef]
- Ruby, A.J.; Jampol, L.M.; Goldberg, M.F.; Schroeder, R.; Anderson-Nelson, S. Choroidal neovascularization associated with choroidal hemangiomas. Arch. Ophthalmol. 1992, 110, 658–661. [Google Scholar] [CrossRef]
- Shields, C.L.; Honavar, S.G.; Shields, J.A.; Cater, J.; Demirci, H. Circumscribed choroidal hemangioma: Clinical manifestations and factors predictive of visual outcome in 200 consecutive cases. Ophthalmology 2001, 108, 2237–2248. [Google Scholar] [CrossRef]
- Hua, R.; Zhao, N.; Hu, Y.; Zhang, C.M.; Chen, L. Circumscribed choroidal hemangioma associated with choroidal neovascularization in a HIV-infected case: Photodynamic therapy and intravitreous ranibizumab. Photodiagnosis Photodyn. Ther. 2014, 11, 441–443. [Google Scholar] [CrossRef]
- Leys, A.M.; Silva, R.; Inhoffen, W.; Tatar, O. Neovascular growth following photodynamic therapy for choroidal hemangioma and neovascular regression after intravitreous injection of triamcinolone. Retina 2006, 26, 693–697. [Google Scholar] [CrossRef]
- Tuncer, S.; Demirci, H.; Shields, C.L.; Shields, J.A. Polypoidal choroidal vasculopathy following photodynamic therapy for choroidal hemangioma. Eur. J. Ophthalmol. 2009, 19, 159–162. [Google Scholar] [CrossRef]
- Witschel, H.; Font, R.L. Hemangioma of the choroid. A clinicopathologic study of 71 cases and a review of the literature. Surv. Ophthalmol. 1976, 20, 415–431. [Google Scholar] [CrossRef] [PubMed]
- Singh, A.D.; Kaiser, P.K.; Sears, J.E. Choroidal hemangioma. Ophthalmol. Clin. N. Am. 2005, 18, 151–161. [Google Scholar] [CrossRef]
- Shirley, M.D.; Tang, H.; Gallione, C.J.; Baugher, J.D.; Frelin, L.P.; Cohen, B.; North, P.E.; Marchuk, D.A.; Comi, A.M.; Pevsner, J. Sturge-Weber syndrome and port-wine stains caused by somatic mutation in GNAQ. N. Engl. J. Med. 2013, 368, 1971–1979. [Google Scholar] [CrossRef] [PubMed]
- Francis, J.H.; Milman, T.; Grossniklaus, H.; Albert, D.; Folberg, R.; Levitin, G.; Coupland, S.; Catalanotti, F.; Rabady, D.; Kandoth, C.; et al. GNAQ Mutations in Diffuse and Solitary Choroidal Hemangiomas. Ophthalmology 2019, 126, 759–763. [Google Scholar] [CrossRef] [PubMed]
- Bichsel, C.A.; Goss, J.; Alomari, M.; Alexandrescu, S.; Robb, R.; Smith, L.E.; Hochman, M.; Greene, A.K.; Bischoff, J. Association of Somatic GNAQ Mutation with Capillary Malformations in a Case of Choroidal Hemangioma. JAMA Ophthalmol. 2019, 137, 91–95. [Google Scholar] [CrossRef]
- Formisano, M.; di Pippo, M.C.; Scuderi, L.; Abdolrahimzadeh, S. Current concepts on diffuse choroidal hemangioma in Sturge Weber syndrome. Ophthalmic Genet. 2021, 42, 375–382. [Google Scholar] [CrossRef]
- Ma, Y.; Zhao, H.; Peng, X. Choroidal neovascularization as a complication of primary vitreous retinal lymphoma. Eur. J. Ophthalmol. 2021, 31, NP31–NP35. [Google Scholar] [CrossRef]
- Chan, C.-C.; Rubenstein, J.L.; Coupland, S.E.; Davis, J.L.; Harbour, J.W.; Johnston, P.B.; Cassoux, N.; Touitou, V.; Smith, J.R.; Batchelor, T.T.; et al. Primary vitreoretinal lymphoma: A report from an International Primary Central Nervous System Lymphoma Collaborative Group symposium. Oncol. 2011, 16, 1589–1599. [Google Scholar] [CrossRef]
- Snip, R.C.; Green, W.R.; Jaegers, K.R. Choroidal nevus with subretinal pigment epithelial neovascular membrane and a positive P-32 test. Ophthalmic Surg. 1978, 9, 35–42. [Google Scholar]
- Damato, B.E.; Foulds, W.S. Tumour-associated retinal pigment epitheliopathy. Eye 1990, 4, 382–387. [Google Scholar] [CrossRef] [PubMed]
- Boyd, S.R.; Tan, D.S.W.; de Souza, L.; Neale, M.H.; Myatt, N.E.; Alexander, R.A.; Robb, M.; Hungerford, J.L.; Cree, I.A. Uveal melanomas express vascular endothelial growth factor and basic fibroblast growth factor and support endothelial cell growth. Br. J. Ophthalmol. 2002, 86, 440–447. [Google Scholar] [CrossRef] [PubMed]
- Cottam, D.W.; Rennie, I.G.; Woods, K.; Parsons, M.A.; Bunning, R.A.; Rees, R.C. Gelatinolytic metalloproteinase secretion patterns in ocular melanoma. Investig. Ophthalmol. Vis. Sci. 1992, 33, 1923–1927. [Google Scholar]

Disclaimer/Publisher’s Note: The statements, opinions and data contained in all publications are solely those of the individual author(s) and contributor(s) and not of MDPI and/or the editor(s). MDPI and/or the editor(s) disclaim responsibility for any injury to people or property resulting from any ideas, methods, instructions or products referred to in the content. |
© 2023 by the authors. Licensee MDPI, Basel, Switzerland. This article is an open access article distributed under the terms and conditions of the Creative Commons Attribution (CC BY) license (https://creativecommons.org/licenses/by/4.0/).
Share and Cite
Di Staso, F.; Di Pippo, M.; Abdolrahimzadeh, S. Choroidal Neovascular Membranes in Retinal and Choroidal Tumors: Origins, Mechanisms, and Effects. Int. J. Mol. Sci. 2023, 24, 1064. https://doi.org/10.3390/ijms24021064
Di Staso F, Di Pippo M, Abdolrahimzadeh S. Choroidal Neovascular Membranes in Retinal and Choroidal Tumors: Origins, Mechanisms, and Effects. International Journal of Molecular Sciences. 2023; 24(2):1064. https://doi.org/10.3390/ijms24021064
Chicago/Turabian StyleDi Staso, Federico, Mariachiara Di Pippo, and Solmaz Abdolrahimzadeh. 2023. "Choroidal Neovascular Membranes in Retinal and Choroidal Tumors: Origins, Mechanisms, and Effects" International Journal of Molecular Sciences 24, no. 2: 1064. https://doi.org/10.3390/ijms24021064
APA StyleDi Staso, F., Di Pippo, M., & Abdolrahimzadeh, S. (2023). Choroidal Neovascular Membranes in Retinal and Choroidal Tumors: Origins, Mechanisms, and Effects. International Journal of Molecular Sciences, 24(2), 1064. https://doi.org/10.3390/ijms24021064

